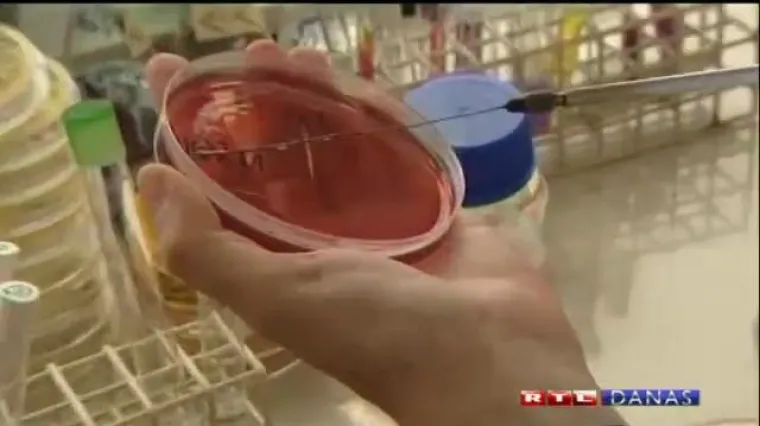
Zaraza se pro&scaron;irila na Ameriku i Če&scaron;ku

Zaraza se proširila na Ameriku i Češku
HAMBURG - Do jučer zdravo povrće danas je sumnjivo. Zbog opasne bakterije europske zemlje pojačale su kontrolu. Iako je većina zaraženih boravila u Njemačkoj na području oko Hamburga, poljski građani su u strahu.
Dok farmeri zbrajaju štetu, iz Njemačke je stigla potvrda da nisu svi zaraženi krastavci iz Španjolske. Španjolska je odmah najvila tužbu protiv vlasti u Hamburgu.
Istovremeno, zaraza se ne prestaje širiti. Zabilježena su dva nova slučaja zaraze u Sjedinjenim američkim državama, a prvi smrtni slučaj zabilježen je i u Češkoj.





403 Forbidden










